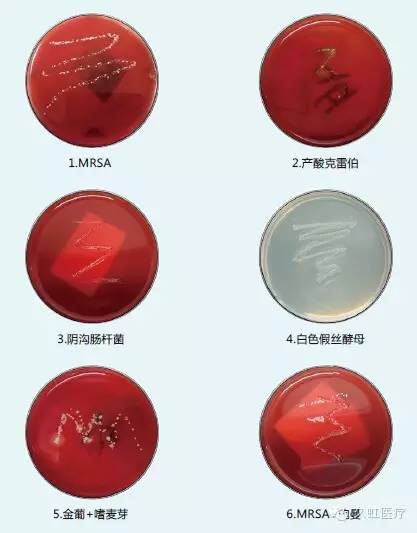

由久虹醫(yī)療與天津醫(yī)科大學總醫(yī)院馮靖合作推出的最新專利產品隔離細胞刷近日已在中國上市。隔離細胞刷的最主要目的是配合介入呼吸病學快速現場評價技術(Rapid On-Site Evaluation; 即玫瑰系統)的使用,能確切有效便捷地評價感染。與傳統的一次性使用細胞刷相比,增加了防污染護套管,小改變大不同,從根部做到了二次防污染,保證獲得“深部”靶標本。
久虹醫(yī)療隔離細胞刷將引領呼吸病學快速感染評價新時代,為呼吸病健康事業(yè)的發(fā)展保駕護航。
隔離細胞刷臨床應用
A.結合“防污染毛刷直接涂碟”技術,明顯提高病原學培養(yǎng)的敏感性和特異性;
B.刷頭細毛軟硬合理,非常適合細胞學制片,一次刷檢可連續(xù)有效制片4~5張;

C.結合“防污染毛刷直接增菌”技術,可將病原學培養(yǎng)的敏感度提高到極限;
D.刷頭細毛取材量大,“防污染毛刷直接涂碟”與細胞學制片可于一次刷檢后一氣呵成,使用極其方便,節(jié)省操作時間與耗材費用。
隔離細胞刷更多優(yōu)勢
Ⅰ、刷頭細毛軟硬合理、彈性與韌性合適、松緊適度、螺旋形設計,既能盡量多的刷取靶標本,又能保護氣道粘膜,減少局部刷檢后出血;

Ⅱ、獨特的“雙環(huán)一柄”設計,即兩個手環(huán)、一個手柄,使得操作簡單有效、方便易學;
Ⅲ、獨特的“保護條”設計,保證運輸途中內管及刷頭穩(wěn)定,不會穿出外管而損傷封堵薄膜;

Ⅳ、獨特的“鋼絲嵌合”設計,刷體質地柔軟而不失彈性,能輕松經內鏡部署到包括雙上葉尖段在內的靶病灶所在支氣管;
Ⅴ、均為“隨棄”設計,使用及其方便,使用后處理方便;
Ⅵ、兼容2.0 mm內鏡工作孔道,適用性強,能用于包括細軟性支氣管鏡(BF-P-260F;Olympus, Tokyo, Japan)在內的多數內鏡;并可與DirectPath ® (CybernetSystem Inc., Tokyo, Japan)和外周徑向超聲系統(EU-M30S; Olympus,Tokyo, Japan),在內的多數導航設備完美結合,確保刷檢到靶病灶。

久虹醫(yī)療——內鏡附件專業(yè)制造商,十二年如一日始終為中國內鏡事業(yè)發(fā)展而努力。我們期待能與更多的內鏡專家合作,研制更多的內鏡新產品,推動醫(yī)療,造福患者!
版權所有 © 常州市久虹醫(yī)療器械有限公司.All Rights Reserved 蘇ICP備12011729號-1
